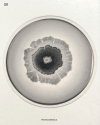
Beautiful Bacteria
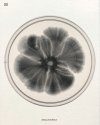
Beautiful Bacteria
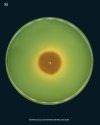
Beautiful Bacteria
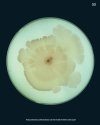
Beautiful Bacteria
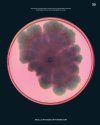
Beautiful Bacteria

Call us (08:30-16:00 UK)
+44 (0) 1803 86 59 13International
+44 (0) 1803 86 59 13Brauchen Sie Hilfe?
HilfeWichtiger Hinweis für Kundinnen und Kunden aus den USA
Datenerfassung und Monitoring
- Aquatic Survey & Monitoring
- Professional Hand & Kick Nets
- Water Testing
- Waders & Aquatic Safety
- View All
- Amphibian & Reptile Survey
- Amphibian Survey & Monitoring
- Reptile Survey & Monitoring
- Scales, Balances & Holding Bags
- View All
Feldführer und Naturgeschichte
Akademische und professionelle Bücher
- Evolutionary Biology
- Evolution
- Human Evolution & Anthropology
- Cladistics, Phylogeny & Taxonomy
- View All
British Wildlife
British Wildlife is the leading natural history magazine in the UK, providing essential reading for both enthusiast and professional naturalists and wildlife conservationists. Published eight times a year, British Wildlife bridges the gap between popular writing and scientific literature through a combination of long-form articles, regular columns and reports, book reviews and letters.
Conservation Land Management
Conservation Land Management (CLM) ist ein Mitgliedermagazin und erscheint viermal im Jahr. Das Magazin gilt allgemein als unverzichtbare Lektüre für alle Personen, die sich aktiv für das Landmanagement in Großbritannien einsetzen. CLM enthält Artikel in Langform, Veranstaltungslisten, Buchempfehlungen, neue Produktinformationen und Berichte über Konferenzen und Vorträge.